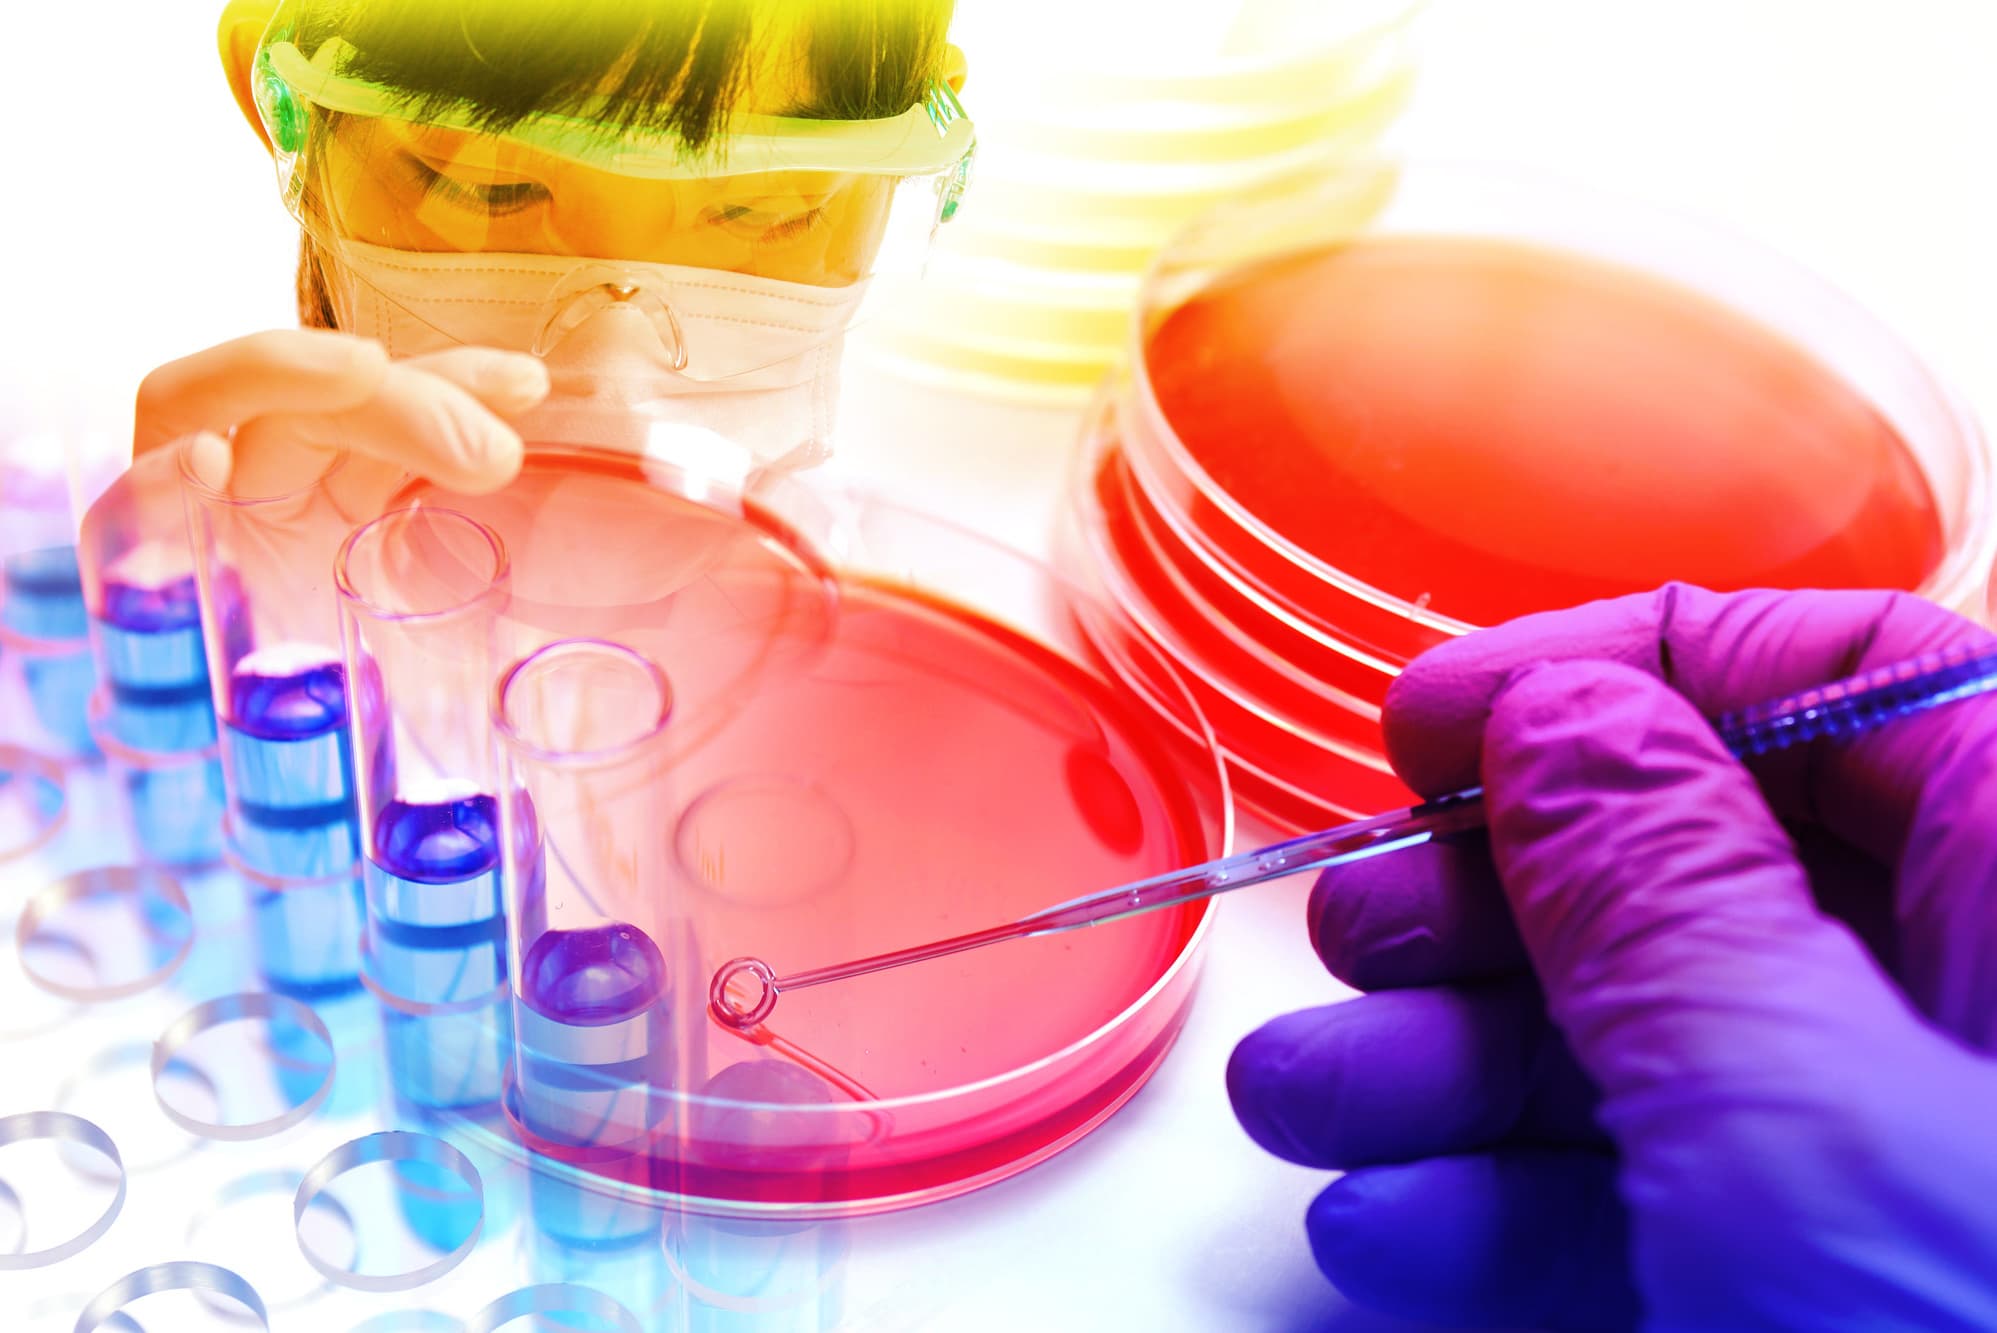

安全で美味しい〝食〟をお届けするために。
食品の微生物学的な安全性の追求
食品の大前提条件は「安全」であること。なかでも,制御が難しい微生物的な安全性を適切に確保することは,食品産業界おいての最重要課題の一つです。Hazard Analysis ans Critical Control Point(HACCP)に代表されるように,現代の食品安全確保は,最終製品の検査によらない,製造プロセスの適切な管理・運用に変わりつつあります。我々はこの製造プロセスの最適化,管理・評価方法を数理的に扱う「予測微生物学」という研究領域を一つの大きな研究の柱に据えております。また,加熱によらない殺菌・静菌技術の開発にも注力しており,他に類を見ないユニークな研究開発を推進しております。

美味しさの追求
食品は安全であるとともに「美味しい」ことが欠かせません。しかし,この美味しさや新鮮さといった指標は,客観的に評価することが難しいものです。しかし,我々人間はこの曖昧な「美味しさ」であったり「新鮮さ」というものを,無意識のうちに判断しております。この人間の判断を仮想的に実現する技術の開発を行っております。また,栽培過程から,収穫後の輸送中における温度管理が品質へ大きく影響することから,この温度履歴を可視化するための積算温度インジケータの開発も行っております。
私たちの研究の概要

食中毒細菌の汚染実態を可視化するソフトウェア
食品環境における食中毒細菌の陽性率および汚染濃度の可視化するソフトウェアを無償公開しています。日本国内で流通している食品を対象とし、2000年〜2025年に報告された約10万検体の検査結果を収録しています。簡単な操作と,データの一覧性の良さで,容易に必要とする食中毒細菌の汚染実態を俯瞰できます。本ソフトウェアは内閣府食品安全委員会の委託研究(JPCAFSC 20252507, JPCAFSC20232307)により開発されました。
食品中における食中毒細菌の陽性率の可視化ソフトウェア
食品中における食中毒細菌の汚染濃度の可視化ソフトウェア
細菌の死滅する過程を予測する
安全な食品を製造する過程において,加熱殺菌は不可欠な技術です。今から100年前(Bigelow, 1920)にはすでに加熱殺菌による細菌の死滅挙動を数理的に記述する試みがなされております。しかし,現代においては安全性だけでなく食品の高品質化が求められており,温和な殺菌条件で最大の効果を発揮するための殺菌の条件の最適化,さらには生物であるがゆえの個々の死滅のバラつきをも考慮した予測が必要となっています。モンテカルロシミュレーション,ベイズ推定,機械学習等の統計数理の技術を駆使して研究を進めております。
さまざま計算ツールを開発しておりますので、こちらからお試しください。


生産から流通,消費に至る過程の温度の見える化
野菜,果物,畜肉,水産物を含むすべての一次生産品は,その生産から流通,消費に至る過程での温度条件が,それらの品質を大きく左右します。そのため,高品質化のために,徹底した温度管理が求められます。現代においては,さまざまな温度記録センサー等が開発され,流通過程における温度をリアルタイムに取得することも可能です。しかし,生産・流通の現場において,瞬時に作業員が把握することはまだ難しいところです。我々は簡易に,その場で温度履歴(積算温度)を目視で確認できるツール,積算温度インジケータの開発に取組んでおります。我々の開発しているメイラード反応を基盤とする技術では,冷凍,冷蔵流通保管から加熱調理に至る幅広い温度帯に対応可能な温度インジケータを提供可能です。
アミノ酸添加で細菌増殖を抑制?
お弁当やお惣菜などの加工食品を安定して流通販売するために,微生物の増殖を抑制して日持ちを延長させる必要があります。保存料は消費者から敬遠されがちですので,それに代わる何かはないか,ということで研究はスタートしております。我々の研究成果では,ある条件下において「トリプトファン」というアミノ酸を少量添加することで,食中毒の原因細菌である腸管出血性大腸菌やサルモネラ,ビブリオといった細菌の増殖を効果的に抑制することを明らかにしています。現在は多様な食品への展開を模索中です。


乾燥食品で食中毒?
乾燥した状態の食品に付着したまま,食中毒菌が1〜3年もの長年にわたり生存可能であり,そういった長期間にわたり生存していた食中毒菌が付着した乾燥食品(ナッツ類,チョコレートなど)を喫食することで,食中毒が発生する事例が世界中で後を絶ちません。不思議なことに,低温(冷蔵庫内)で保存すると食中毒菌が平気で2年以上長生きします。我々はこの根本原因を明らかにすべく,細菌細胞の物性変化(ガラス転移)に注目をして,乾燥過程において細菌細胞が,物理的にどう変化しているのかを明らかにしようとしています。
アボカドの内部品質の評価
アボカドの食べごろの判断は難しい。実際に切ってみないと中の硬さがわからない。また,可食部分の一部が黒変していて食べられない状態になる場合もある。スマートフォンカメラの画像と近赤外分光法を用い迅速にアボカドの内部の硬さ,黒変を評価する。選果場の目利きに変わって,アボカドの品質の評価を行うことを目指している。


食べ物に対する主観的な感覚の見える化
人は青果物の何を見て品質や鮮度の良し悪しを判断しているのでしょうか?写真に映る青果物の品質の良し悪しを繰り返し比較し、統計解析することで、人々が品質評価においてどのような要素を重要視しているのかを解釈します。具体的には、品質や鮮度、傷や曲がりといった曖昧なことばに対する人の感覚を数理モデルで説明します。北海道大学総合博物館に本研究の体験ができるソフトウェアを展示しています。
食品微生物挙動データベースMRV
食品環境における各種細菌の増殖条件の探索を可能とするデータベースMRV(Microbial Responses Viewer)を管理運営しています。農研機構 食品研究部門との共同研究として開発されました。簡単な操作と,データの一覧性の良さで,容易に必要とする細菌増殖抑制条件を見出すことができます。食品産業界において活用されております。